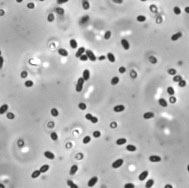

アシディフィリウム属細菌
(Acidiphilium multivorum AIU301T(= NBRC 100883T))
Acidiphilium multivorum AIU301Tは岩手県の松尾鉱山跡の強酸性廃水から分離された好酸性の酸素非発生型好気性光栄養細菌です。Alpha-proteobacteriaに属するAcidiphlium属は酸性環境下で様々な金属に対する高い耐性能を持ち、その生育には強い酸性環境を必要とすることで知られています。Acidiphilium multivorum AIU301Tもニッケルや亜鉛、カドミウム、銅の各イオンに対する耐性を持つ他に、ヒ酸や亜ヒ酸に対する耐性を示すことも確認されています。また、Acidiphilium multivorum AIU301Tは主要なバクテリオクロロフィルとして、亜鉛バクテリオクロロフィルを持つ特徴があり、このユニークな特徴はAcidiphlium属を含む好気好酸性の proteobacteriaに限られています。
ゲノム解析の結果、A. multivorum AIU301Tのゲノムは1本の環状染色体、8本の環状プラスミドpACMV1、pACMV2、pACMV3、pACMV4、pACMV5、pACMV6、pACMV7、pACMV8の9つの複製単位からなることが明らかになりました。これらのゲノム上には、金属耐性に関与すると予想される多くのトランスポーターに関連する遺伝子やヒ素耐性に関与すると考えられる3つのオペロンが含まれることが分かりました。
また、近縁のAcidipphilium cryptum JF-5の染色体との間で非常に高いシンテニーが見られましたが、A. multivorum AIU301Tの染色体のみに存在する225-kbの領域中には光合成遺伝子クラスターや多くのInsertion Sequenceが見つかっております。
本菌のゲノム解析結果を基に、好酸性バクテリアの金属耐性能や好酸性適応についての解析が進み、バイオレメディエーションへの技術の開発に繋がることが期待されます。
Acidiphilium multivorum AIU301T 電子顕微鏡写真
内野 (NITE NBRC) 撮影
| ゲノムサイズ(bps) | 4,214,744 |
|---|---|
| ORF | 3,949 |
| GC含量(%) | 66.97 |
| データベース | DOGAN |
| NBRC番号 | 100883 |
| 代表共同研究先 | 学校法人 早稲田大学 |
- 塩基配列決定時に使用したゲノムDNAクローンの分譲について
- バイオテクノロジーセンター(NBRC)では、塩基配列決定時に使用したゲノムDNAクローンの分譲を行っています。
お問い合わせ
- 独立行政法人製品評価技術基盤機構 バイオテクノロジーセンター バイオ技術評価・開発課(東京)
-
TEL:03-3481-1936
住所:〒151-0066 東京都渋谷区西原2-49-10 地図
お問い合わせフォームへ








